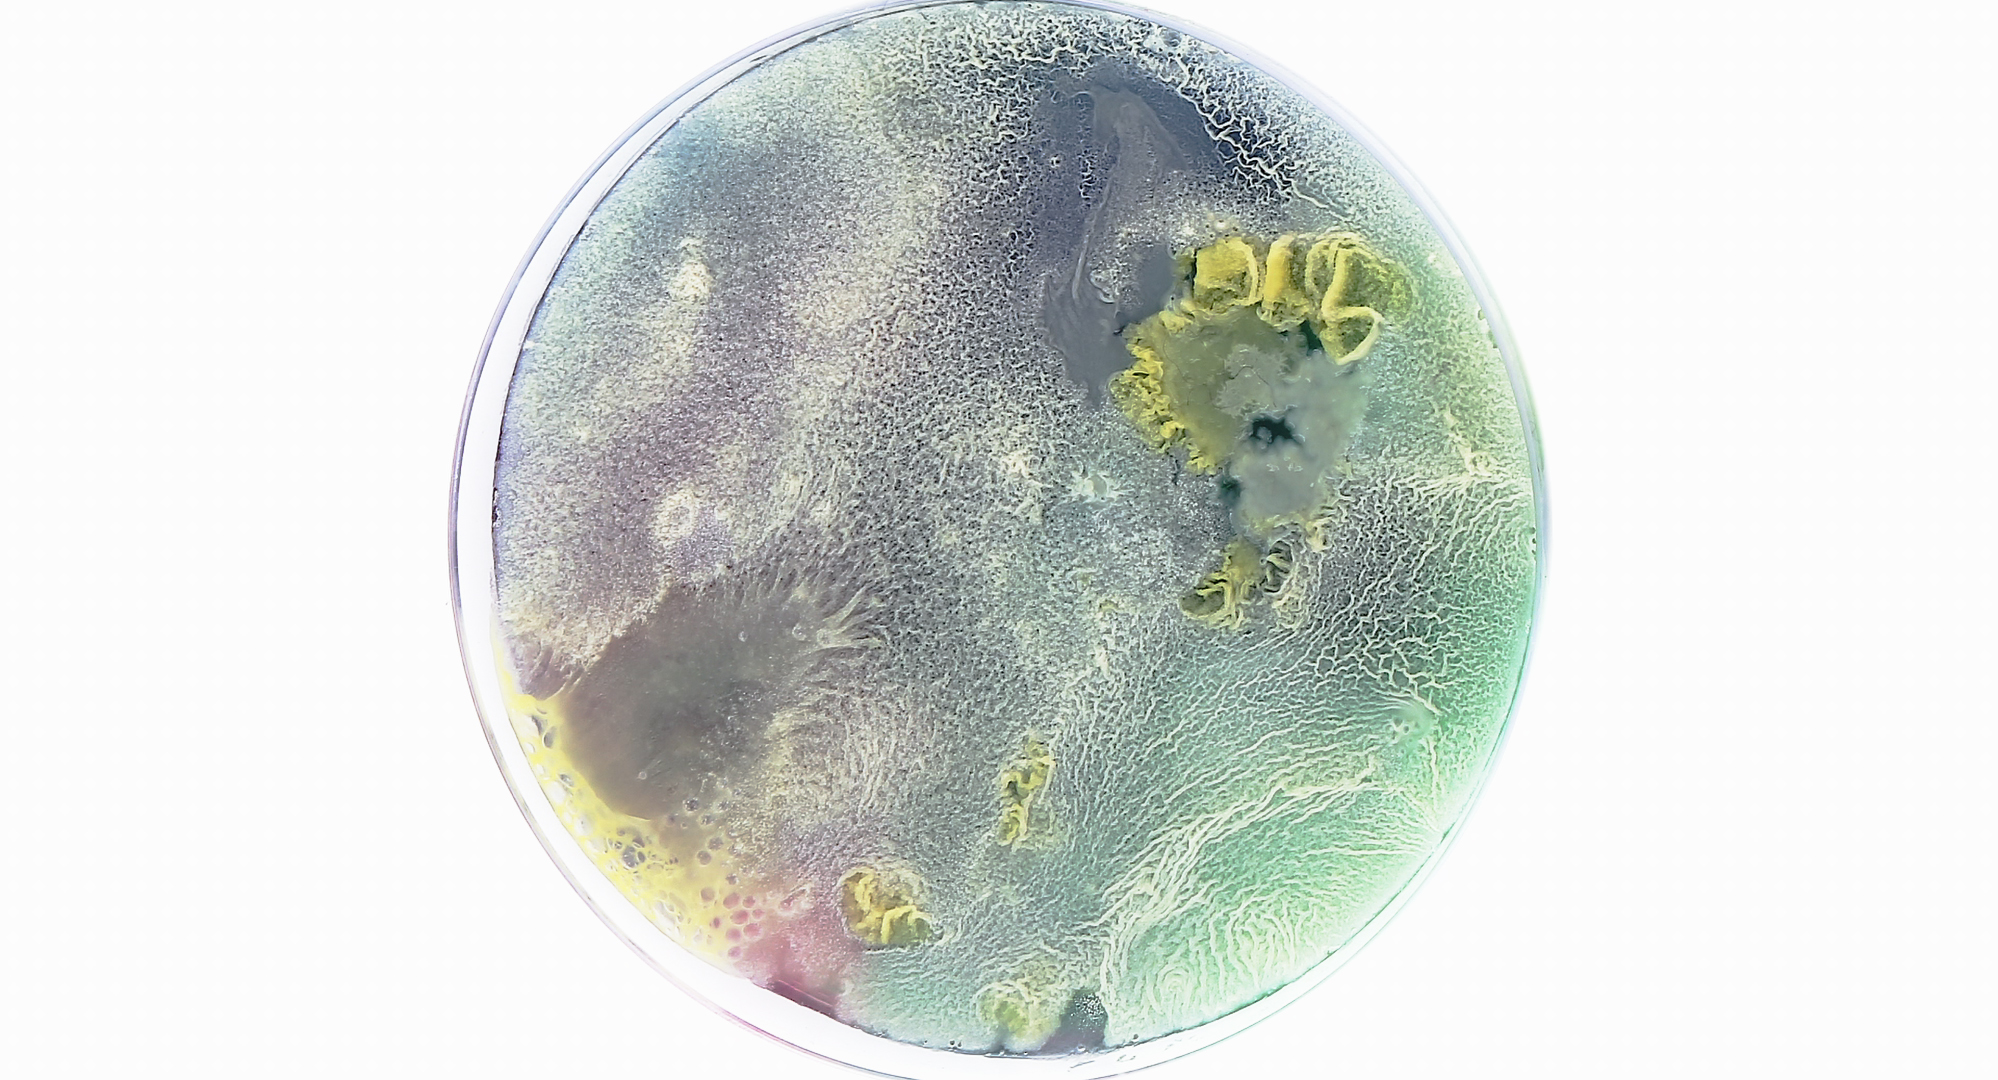
Still

The Mushroom Speaks
The Mushroom Speaks unfolds the healing qualities of fungi and their ability to regenerate. This personal journey takes us on a walk alongside parasites, symbionts and decomposers offering ideas of both interconnectedness and collaboration. Driven by a vision of resistance, the encounters seek possibilities of renewal and question what connects us when the world seems to be falling apart.
With mushrooms and their allies the film invites to imagine a mycocultural (r)evolution. What if the fungus could help us address and radically change our relationship to this world?
Dir. Marion Neumann - 89min - 2021 - Switzerland
"expert interviews are juxtaposed with more abstract images, which zoom in on germinating spores or colourful moulds growing in laboratory dishes....The patience, care and sheer awe that emanate from how Neumann observes these fungal configurations is inspirational, nudging us to inspect our surrounding environment with the same rigour and curiosity." - The Guardian
"Ecological science fiction and natural philosophy in a beautiful and generous film about mushrooms and about what we can learn if we listen to nature." - CPH DOX
"destabilising, dream-like images...create a sense of confusion and necessary stupor, ultimately allowing us to reflect upon the way we exist in the world and on our complex and often conflictual relationship with nature." - Cineuropa
"Under each mushroom, there hides a network that is invisible to the naked eye and that is evolving beneath our feet. The Mushroom Speaks ventures into this underground world, to hear what these organisms have to tell us." - Visions du Reel
-
The Mushroom Speaks
Dir. Marion Neumann - 89min - 2021 - Switzerland
The Mushroom Speaks unfolds the healing qualities of fungi and their ability to regenerate. This personal journey takes us on a walk alongside parasites, symbionts and decomposers offering ideas of both interconnectedness and collaboration. Driven...
Extras
-
The Mushroom Speaks - Trailer
THE MUSHROOM SPEAKS traces possible alliances with the fungal reign. As if in an uprising of spores, the en- counters of the film explore the theme of renewal, and question what connects us when the world seems to be falling apart.